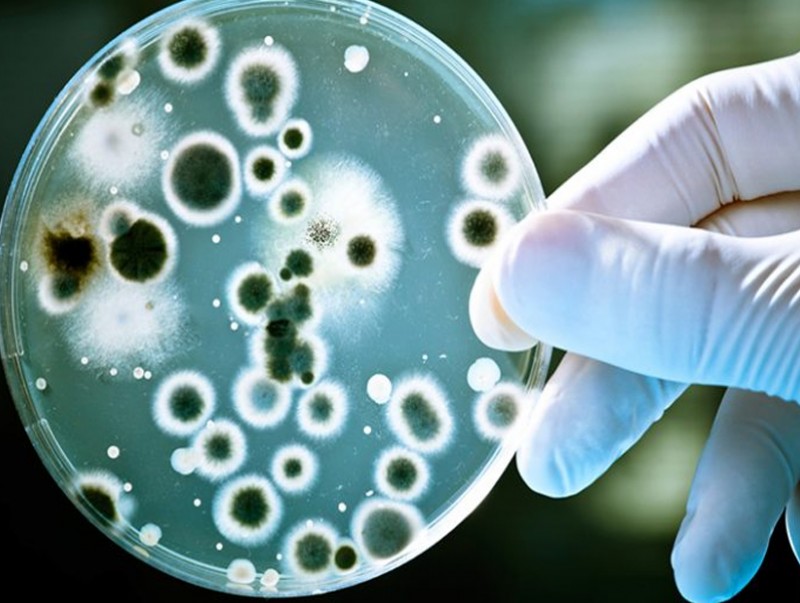

ДЭМБ-ын удирдлагууд сүүлийн үед холер, эбола зэрэг халдварт өвчин дэлхийн улс орнуудад хурдацтай тархаад байгаа нь сэтгэл түгшээсэн асуудал болж байгааг лхагва гарагт Женев хотноо хийсэн хэвлэлийн бага хурлын үеэр мэдэгджээ.
ДЭМБ-ын тэргүүн Тедрос Адханом Гебрейесус "Угандад эболагийн халдвар анхаарал татсан асуудал болж, батлагдсан 60 тохиолдол, магадллал өндөр 20 тохиолдол бүртгэгдсэнээс 44 нь амиа алдаж, 25 хүн эдгэрсэн мэдээлэлтэй байна. Бид мөн халдварын илрээгүй гинжин холбоо, тархалт байж болзошгүй гэж санаа зовниж байна" гэж мэдээлжээ.
Мөн ДЭМБ-ын Эрүүл мэндийн яаралтай тусламжийн хөтөлбөрийн гүйцэтгэх захирал Майкл Райан "Энэ бол Суданаас гаралтай эбола вирус бөгөөд Баруун Африк, Конго улсад боловсруулсан вакцинууд нь энэ төрлийн вируст үр дүнгүй байна. Бидэнд одоогоор гурван нэр дэвшигч вакцин байгаагаас нэн даруй авах боломжтой хоёр вакцин бий. Энэ халдвартай яаралтай тэмцэх ажлуудыг хийж байна" гэжээ.
Үүнээс гадна холер өвчин 29 улсад дэгдсэнээс 13 нь өнгөрсөн жил тархалтгүй байсан улсууд байгаа нь санаа зовнисон асуудал болоод байгааг ДЭМБ-ын тэргүүн мөн энэ үеэр мэдээлсэн байна.
Тэрбээр “Холер өвчин нь маш аюултай. Нэг өдрийн дотор үхэлд хүргэх аюултай тул хоёр тун вакцинаар урьдчилан сэргийлэх нь хамгийн найдвартай. Гэвч одоогийн байдлаар улс орнуудад эдгээр өвчин хурдтай тархаж байгаа нь вакцины хүртээмжгүй байдал үүсгэсэн учраас аль болох олон хүнд хүрч, тэднийг хамгаалахын тулд нэг тунгаар дархлаажуулах бодлого ойрын хугацаанд хэрэгжүүлэхээр шийдвэрлэсэн" гэдгийг мэдэгджээ.
| ДЭМБ: Холер, эбола зэрэг халдварт өвчин ихсэж байна | ||
| Үзсэн: 635 | Mongolian National Broadcaster |


 Үндэсний телевиз
Үндэсний телевиз

























































































































 Р.Слава
Р.Слава

 Б.Цоожчулуунцэцэг
Б.Цоожчулуунцэцэг

 М.Тодхүү
М.Тодхүү





Сэтгэгдэл бичих:
АНХААРУУЛГА: Уншигчдын бичсэн сэтгэгдэлд MNB.mn хариуцлага хүлээхгүй болно. ТА сэтгэгдэл бичихдээ хууль зүйн болон ёс суртахууны хэм хэмжээг хүндэтгэнэ үү. Хэм хэмжээг зөрчсөн сэтгэгдэлийг админ устгах эрхтэй. Сэтгэгдэлтэй холбоотой санал гомдолыг 70127055 утсаар хүлээн авна.